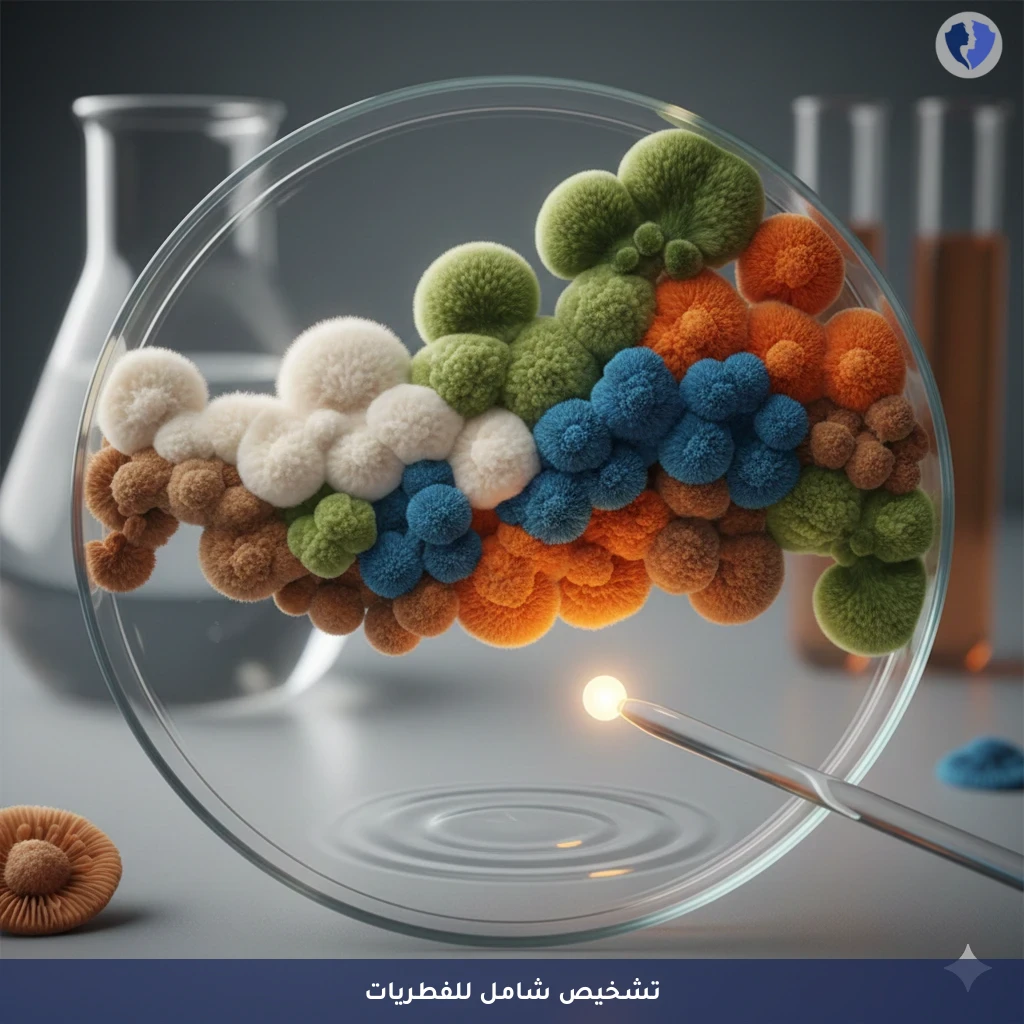
زراعة وفحص حساسية الفطريات - مزرعة واختبار حساسية الفطريات

تفاصيل الخدمة
زراعة وفحص حساسية الفطريات - مزرعة واختبار حساسية الفطريات
فحص ميكروبيولوجي متخصص يتم فيه زراعة عينة سريرية (من الدم، الجلد، الأنسجة العميقة، السوائل المعقمة، إلخ) على أوساط زرعية مغذية خاصة بالفطريات (مثل سابورو دكستروز آغار). يهدف إلى عزل وتحديد هوية الفطريات المسببة للعدوى (خمائر أو فطريات خيطية). يتضمن الاختبار تحديد الحساسية للمضادات الفطرية (Antifungal Susceptibility Testing) لتحديد الدواء الأكثر فعالية في علاج العدوى، خاصة في الحالات الشديدة أو لدى مرضى ضعف المناعة.